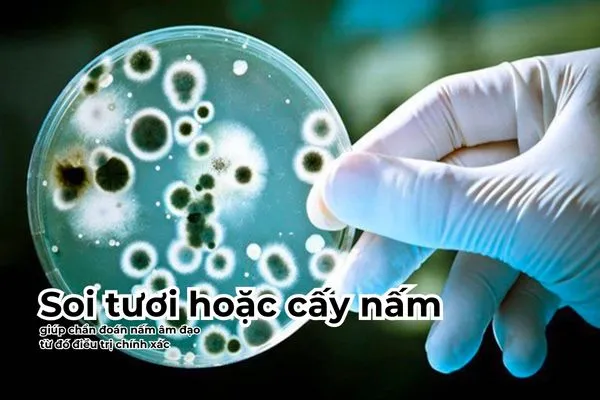
Thuốc kháng nấm được sử dụng để điều trị sau khi chẩn đoán nấm âm đạo

Nấm âm đạo là tình trạng nhiễm trùng âm đạo do nấm gây ra, phổ biến nhất là nấm Candida. Có nhiều dấu hiệu cảnh báo giúp chị em nhận biết tình trạng này. Tuy nhiên, các dấu hiệu cũng thường bị nhầm lẫn với những bệnh lý phụ khoa khác. Cùng tìm hiểu để nhận biết sớm các dấu hiệu nấm âm đạo qua bài viết sau nhé!
Nấm âm đạo là gì?
Nấm âm đạo là bệnh phụ khoa phổ biến ở nhiều chị em phụ nữ. Loại nấm chủ yếu gây bệnh ở âm đạo là Candida albicans.
Ở trạng thái khỏe mạnh, âm đạo có cơ chế tự bảo vệ và cân bằng hệ vi sinh. Do đó, các hại khuẩn như nấm không thể phát triển gây bệnh. Tuy nhiên, một số yếu tố bên trong và bên ngoài có thể tác động đến âm đạo làm mất sự cân bằng này, từ đó tạo điều kiện cho nấm sinh sôi và phát triển mạnh mẽ.
Các yếu tố nguy cơ có thể kể đến là:
- Phụ nữ có thai
- Phụ nữ mắc bệnh đái tháo đường, suy giảm miễn dịch
- Đang sử dụng thuốc corticoid, thuốc kháng sinh
- Vệ sinh không đúng cách, mặc đồ lót ẩm ướt, bó sát
- Thiếu hụt lợi khuẩn

5 dấu hiệu nhiễm nấm âm đạo
Nấm âm đạo đặc trưng bởi sự ngứa ngáy, sưng đỏ và tiết dịch vùng kín. Các dấu hiệu này có thể sẽ trở nên nghiêm trọng hơn trước thời gian hành kinh. Đôi khi, ngoài âm đạo, triệu chứng nấm còn được ghi nhận ở miệng, tay,…
Tuỳ theo mức độ bệnh mà các dấu hiệu sẽ biểu hiện khác nhau, cụ thể là:
1. Ngứa âm đạo
Ngứa ngáy, châm chích là dấu hiệu nấm âm đạo phổ biến và gần như xuất hiện sớm nhất. Chị em có thể cảm thấy ngứa ở vùng âm hộ bên ngoài hoặc ngứa sâu trong âm đạo. Cảm giác ngứa âm đạo thường xảy ra bất chợt hoặc châm chích âm ỉ kéo dài.
Tuy nhiên, chị em nên hạn chế dùng tay hoặc vật lạ để gãi vùng kín khi ngứa. Bởi điều này có thể làm thể làm trầm trọng thêm tình trạng viêm nhiễm. Việc gãi vùng kín còn gây ra các vết xước khiến nấm và vi khuẩn dễ dàng xâm nhập hơn.
| Tham khảo ngay: Nguyên nhân và 7 cách giảm ngứa vùng kín hiệu quả |

2. Sưng âm đạo
Ngoài ngứa ngáy, chị em bị nấm âm đạo còn xuất hiện triệu chứng sưng do viêm. Dấu hiệu sưng sẽ mờ nhạt hơn nếu tình trạng nấm âm đạo không quá nghiêm trọng. Ngoài dấu hiệu nấm âm đạo là sưng tấy, chị em còn có thể cảm thấy:
- Niêm mạc hoặc da nổi ban đỏ
- Vùng kín nóng và đau
- Phù nề
- Xuất hiện các vết xước, loét
Nấm không chỉ gây sưng niêm mạc âm đạo, môi âm đạo mà còn lan ra mu và bẹn. Khi thấy dấu hiệu sưng không thuyên giảm, chị em nên chủ động đến gặp bác sĩ để thăm khám.

3. Khí hư màu trắng đục
Khí hư (dịch tiết âm đạo) là chất được tiết ra giúp làm trơn, làm sạch và bảo vệ âm đạo. Khi mắc các bệnh lý âm đạo, khí hư sẽ thay đổi giúp chị em nhận biết sự bất thường.
Thông thường, dấu hiệu nấm âm đạo là tiết nhiều khí hư màu trắng đục hoặc màu vàng. Dịch tiết có màu như sữa này thường ở dạng đông vón, lợn cợn và bám đầy thành âm đạo. Chị em bị nấm âm đạo sẽ tiết khí hư nhiều hơn, mùi nặng hơn.
Khí hư màu trắng đục được xem là dấu hiệu nấm âm đạo tương đối dễ nhận biết. Do đó, khi nhận thấy lượng khí hư có mùi và màu sắc bất thường nghi ngờ do nấm, chị em nên đến gặp bác sĩ phụ khoa để chẩn đoán nguyên nhân một cách chính xác. Từ đó có cách xử lý phù hợp để kiểm soát triệu chứng và điều trị bệnh.

4. Đau khi quan hệ
Đi kèm với triệu chứng sưng tấy âm đạo khi bị nấm thường là cảm giác đau âm đạo. Tuy nhiên, mức độ đau có thể nhẹ hoặc nặng tuỳ theo tình trạng bệnh. Cơn đau thường sẽ tăng lên khi có sự tác động vào âm đạo. Chẳng hạn như khi:
- Quan hệ tình dục, nhất là quan hệ tình dục mạnh bạo
- Đi vệ sinh
- Vệ sinh vùng kín.
Khi bị nấm âm đạo quá nặng, cơn đau có thể lan ra khắp vùng kín và vùng chậu. Một số ít trường hợp thậm chí gây đau bụng dưới và đau lưng, đau bẹn, đùi,…

5. Khó tiểu
Do cấu trúc niệu đạo ở nữ giới tương đối ngắn và nằm cạnh âm đạo nên nấm có thể di chuyển từ âm đạo vào hệ tiết niệu và gây ra một số bất thường tại đây.
Những rối loạn tiết niệu có thể gặp phải khi bị nấm là khó tiểu, bí tiểu, tiểu đau,… Những triệu chứng này chứng tỏ nấm âm đạo đã gây ảnh hưởng đến đường niệu. Lúc này, chị em nên đến gặp bác sĩ thăm khám để điều trị kịp thời.
Cách trị nấm âm đạo
Khi có các dấu hiệu nghi ngờ, bác sĩ sẽ tiến hành thăm khám để định hướng nấm âm đạo. Bên cạnh việc hỏi bệnh và khám bằng mỏ vịt, một số cận lâm sàng cũng có thể được chỉ định.
- Soi tươi dịch âm đạo dưới kính hiển vi để xác định tình trạng nhiễm nấm.
- Cấy nấm để biết chính xác loại nấm mà người bệnh đang mắc phải.
Nếu đã xác định bị nấm âm đạo, chị em sẽ được bác sĩ chỉ định điều trị bằng thuốc. Nhóm thuốc được sử dụng là thuốc kháng nấm, phổ biến nhất là fluconazole, terconazole, miconazole, nystatin, clotrimazole,... Các thuốc này có thể được sử dụng dưới nhiều dạng khác nhau như:
- Viên trứng đặt âm đạo
- Thuốc mỡ bôi tại chỗ
- Thuốc đường uống tác dụng toàn thân (cho trường hợp nhiễm nấm âm đạo nặng hơn).
[H2] Phòng ngừa nấm âm đạo
Nấm âm đạo là bệnh phụ khoa vô cùng phổ biến. Đặc biệt là ở đối tượng phụ nữ đã lập gia đình và phụ nữ mang thai. Do đó, việc phòng ngừa nấm âm đạo từ sớm giúp chị em giảm thiểu nhiều biến chứng nguy hiểm.
Chị em có thể tham khảo ngay một số biện pháp sau để phòng ngừa nấm âm đạo hiệu quả:
- Vệ sinh vùng kín sạch sẽ, đúng cách
- Mặc quần lót thoáng khí, không mặc quần quá bó hoặc ẩm ướt
- Không nên để áo quần, đặc biệt là quần áo bị ẩm ướt
- Tránh các tác động mạnh đến âm đạo như thụt rửa, quan hệ tình dục mạnh bạo, thủ dâm,…
- Không nên ngâm bồn nước nóng lâu, nên tắm bằng vòi sen
- Bổ sung lợi khuẩn cho âm đạo khoẻ mạnh.
- Không chọn những sản phẩm dung dịch vệ sinh, băng vệ sinh gây kích ứng.

Dấu hiệu nấm âm đạo thường không khó nhận biết nhưng dễ bị bỏ qua do chủ quan. Chị em nên đến gặp bác sĩ ngay khi các triệu chứng ảnh hưởng đến cuộc sống thường ngày. Nếu thấy hữu ích, hãy chia sẻ bài viết này đến những người phụ nữ thân yêu để phát hiện sớm dấu hiệu nấm âm đạo nếu có nhé!























